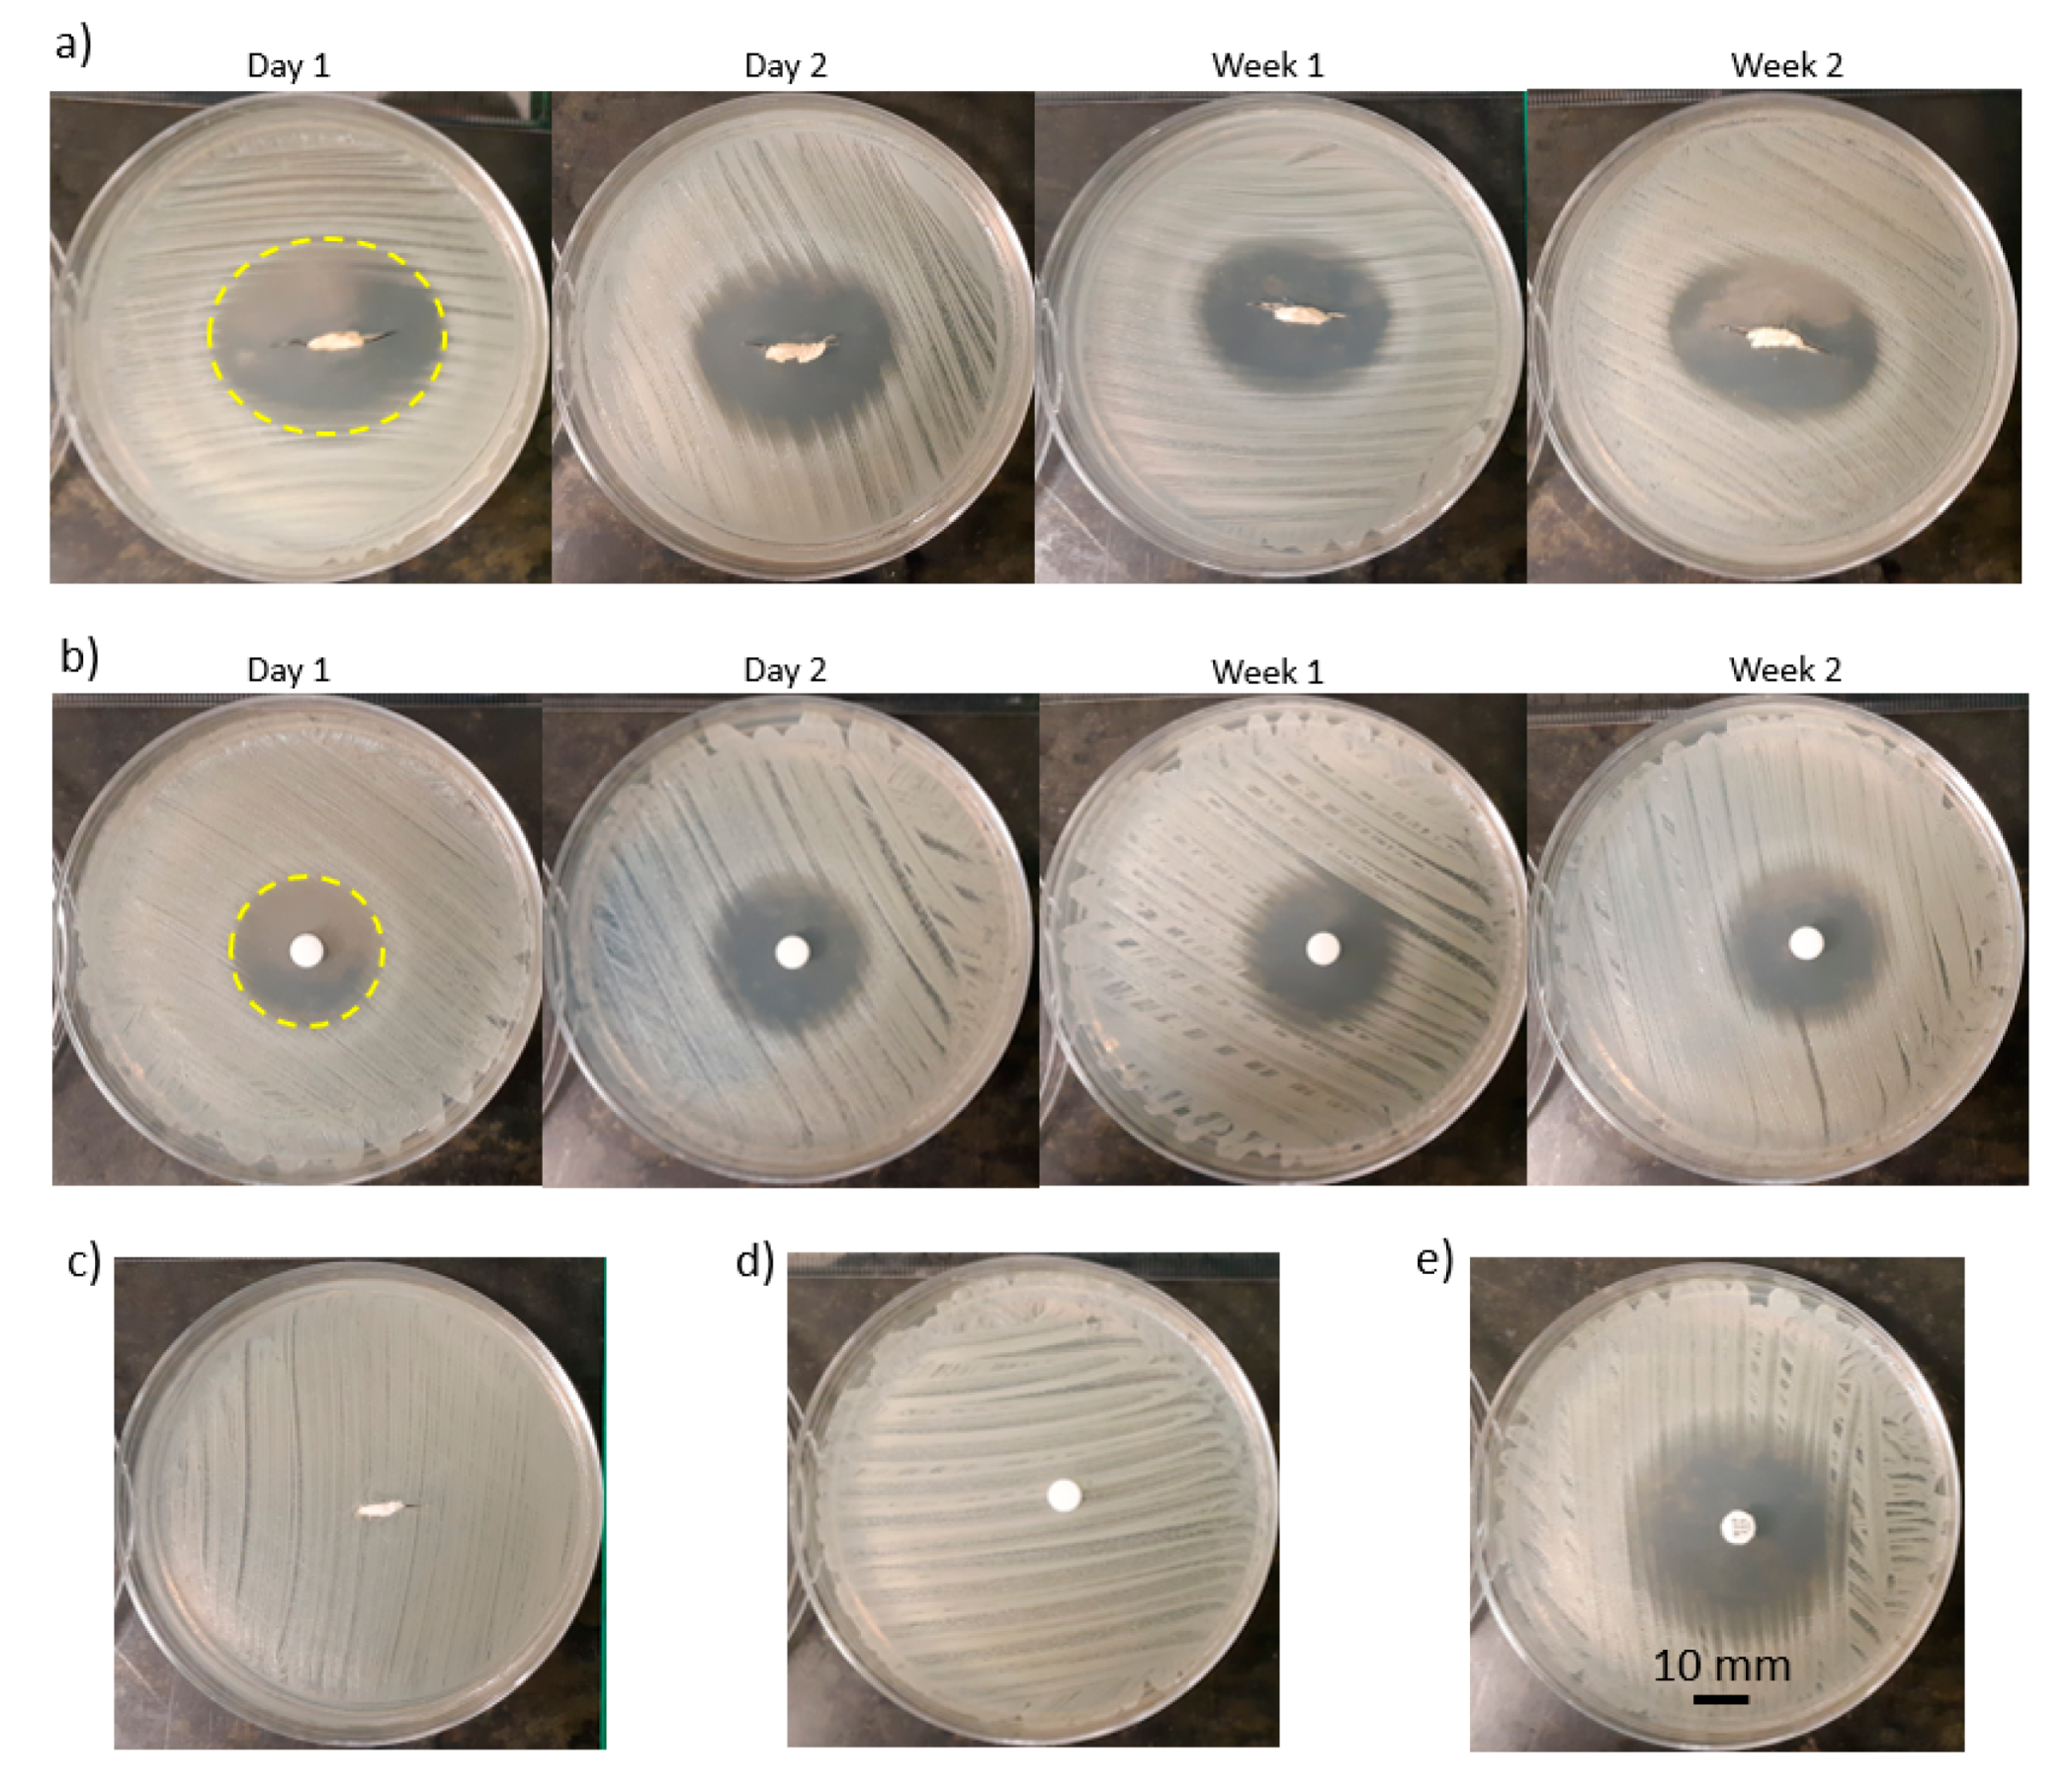
Pharmaceutics 12 00901 g004

Development of 3D Printed Drug-Eluting Scaffolds for Preventing Piercing Infection
Abstract
:1. Introduction
2. Materials and Methods
2.1. Preparation of Biomaterial Inks
2.2. 3D Printing
2.3. Post-Printing Requirements
2.4. In Vitro Drug Release Study
2.5. In Vitro Mupirocin Efficacy
3. Results and Discussion
3.1. Solvent Removal
3.2. Drug Integrity Study
3.3. Zone of Inhibition Characterization
3.4. Effects of Drug Concentration on Drug Release
3.5. Effects of PLGA Composition on Drug Release
3.6. Release Potential (RP) and Total Zone of Inhibition
3.7. Mechanical Integrity
4. Conclusions
Author Contributions
Funding
Acknowledgments
Conflicts of Interest
References
- Ellis, A.D. A Picture is Worth One Thousand Words: Body Art in the Workplace. Empl. Responsib. Rights J. 2015, 27, 101–113. [Google Scholar] [CrossRef]
- Armstrong, M.L.; Tustin, J.; Owen, D.C.; Koch, J.R.; Roberts, A.E. Body Art Education. J. Sch. Nurs. 2014, 30, 12–18. [Google Scholar] [CrossRef]
- Fijalkowska, M.; Kasielska, A.; Antoszewski, B. Variety of complications after auricle piercing. Int. J. Dermatol. 2014, 53, 952–955. [Google Scholar] [CrossRef]
- Armstrong, M.L.; Koch, J.R.; Saunders, J.C.; Roberts, A.E.; Owen, D.C. The hole picture: Risks, decision making, purpose, regulations, and the future of body piercing. Clin. Dermatol. 2007, 25, 398–406. [Google Scholar] [CrossRef] [PubMed]
- Covello, F.; Salerno, C.; Giovannini, V.; Corridore, D.; Ottolenghi, L.; Vozza, I. Piercing and Oral Health: A Study on the Knowledge of Risks and Complications. Int. J. Environ. Res. Public Health 2020, 17, 613. [Google Scholar] [CrossRef] [Green Version]
- Holbrook, J.; MinochaAnne, J.; Laumann, A. Body Piercing Complications and Prevention of Health Risks, 1st ed. Am. J. Clin Dermatol. 2012, 13, 1–17. [Google Scholar] [CrossRef] [PubMed]
- Inchingolo, F.; Tatullo, M.; Abenavoli, F.M.; Marrelli, M.; Inch-Ingolo, A.D.; Palladino, A.; Inchingolo, A.M.; Dipalma, G. Oral piercing and oral diseases: A short time retrospective study. Int. J. Med. Sci. 2011, 8, 649–652. [Google Scholar] [CrossRef] [PubMed] [Green Version]
- Lawrence, C.; Jenkins, K.A.D. Complications of Genital Piercings. Anaplastology 2013, 2. [Google Scholar] [CrossRef]
- Hogan, L.; Armstrong, M.L. Body piercing: More than skin deep. Skin Ther. Lett. 2009, 14, 4–7. [Google Scholar]
- Sosin, M.; Weissler, J.M.; Pulcrano, M.; Rodriguez, E.D. Transcartilaginous ear piercing and infectious complications: A systematic review and critical analysis of outcomes. Laryngoscope 2015, 125, 1827–1834. [Google Scholar] [CrossRef] [PubMed]
- Patel, M.; Cobbs, C.G. Infections from Body Piercing and Tattoos. In Infections of Leisure; ASM Press: Washington, DC, USA, 2016; pp. 307–323. [Google Scholar]
- Sawada, Y.; Ara, M.; Yotsuyanagi, T.; Sone, K. Treatment of dermal depth burn wounds with an antimicrobial agent-releasing silicone gel sheet. Burns 1990, 16, 347–352. [Google Scholar] [CrossRef]
- Zhu, Y.; Xu, C.; Zhang, N.; Ding, X.; Yu, B.; Xu, F.-J. Polycationic Synergistic Antibacterial Agents with Multiple Functional Components for Efficient Anti-Infective Therapy. Adv. Funct. Mater. 2018, 28, 1706709. [Google Scholar] [CrossRef]
- Gao, Y.; Song, N.; Liu, W.; Dong, A.; Wang, Y.; Yang, Y. Construction of Antibacterial N-Halamine Polymer Nanomaterials Capable of Bacterial Membrane Disruption for Efficient Anti-Infective Wound Therapy. Macromol. Biosci. 2019, 19, 1800453. [Google Scholar] [CrossRef]
- Merrell, J.G.; McLaughlin, S.W.; Tie, L.; Laurencin, C.T.; Chen, A.F.; Nair, L.S. Curcumin-loaded poly(ε-caprolactone) nanofibres: Diabetic wound dressing with anti-oxidant and anti-inflammatory properties. Clin. Exp. Pharmacol. Physiol. 2009, 36, 1149–1156. [Google Scholar] [CrossRef] [PubMed] [Green Version]
- Tamer, T.M.; Valachová, K.; Hassan, M.A.; Omer, A.M.; El-Shafeey, M.; Mohy Eldin, M.S.; Šoltés, L. Chitosan/hyaluronan/edaravone membranes for anti-inflammatory wound dressing: In vitro and in vivo evaluation studies. Mater. Sci. Eng. C 2018, 90, 227–235. [Google Scholar] [CrossRef] [PubMed]
- Nishiguchi, A.; Taguchi, T. Designing an anti-inflammatory and tissue-adhesive colloidal dressing for wound treatment. Colloids Surfaces B Biointerfaces 2020, 188, 110737. [Google Scholar] [CrossRef] [PubMed]
- Bechert, K.; Abraham, S.E. Pain Management and Wound Care. J. Am. Coll. Certif. Wound Spec. 2009, 1, 65–71. [Google Scholar] [CrossRef] [Green Version]
- Holbert, M.D.; Griffin, B.R.; McPhail, S.M.; Ware, R.S.; Foster, K.; Bertoni, D.C.; Kimble, R.M. Effectiveness of a hydrogel dressing as an analgesic adjunct to first aid for the treatment of acute paediatric thermal burn injuries: Study protocol for a randomised controlled trial 11 Medical and Health Sciences 1103 Clinical Sciences 11 Medical and Health Sciences 1117 Public Health and Health Services. Trials 2019, 20, 1–13. [Google Scholar] [CrossRef]
- Muchowska, A.; Redkiewicz, P.; Różycki, K.; Matalińska, J.; Lipiński, P.F.J.; Czuwara, J.; Kosson, P. The analgesic hybrid of dermorphin/substance P and analog of enkephalin improve wound healing in streptozotocin-induced diabetic rats. Wound Repair Regen. 2020, 28, 177–184. [Google Scholar] [CrossRef]
- Strock, L.L.; Lee, M.M.; Rutan, R.L.; Desai, M.H.; Robson, M.C.; Herndon, D.N.; Heggers, J.P. Topical Bactroban (Mupirocin). J. Burn Care Rehabil. 1990, 11, 454–459. [Google Scholar] [CrossRef]
- Ormiston, M.C.; Seymour, M.T.J.; Venn, G.E.; Cohen, R.I.; Fox, J.A. Controlled trial of Iodosorb in chronic venous ulcers. Br. Med. J. 1985, 291, 308–310. [Google Scholar] [CrossRef] [PubMed] [Green Version]
- Demirtas, Y.; Yagmur, C.; Soylemez, F.; Ozturk, N.; Demir, A. Management of split-thickness skin graft donor site: A prospective clinical trial for comparison of five different dressing materials. Burns 2010, 36, 999–1005. [Google Scholar] [CrossRef]
- Malpass, K.G.; Snelling, C.F.T.; Tron, V. Comparison of Donor-Site Healing under Xeroform and Jelonet Dressings: Unexpected Findings. Plast. Reconstr. Surg. 2003, 112, 430–439. [Google Scholar] [CrossRef] [PubMed]
- Bellaud, G.; Canestri, A.; Gallah, S.; Merlant, M.; Cousseau, S.; Lebrette, M.G.; Slama, L.; Pialoux, G. Chondrites bactériennes de l’oreille post-piercing. Med. Mal. Infect. 2017, 47, 26–31. [Google Scholar] [CrossRef] [PubMed]
- Zou, P.; Lee, W.H.; Gao, Z.; Qin, D.; Wang, Y.; Liu, J.; Sun, T.; Gao, Y. Wound dressing from polyvinyl alcohol/chitosan electrospun fiber membrane loaded with OH-CATH30 nanoparticles. Carbohydr. Polym. 2020, 232, 115786. [Google Scholar] [CrossRef]
- Wutticharoenmongkol, P.; Hannirojram, P.; Nuthong, P. Gallic acid-loaded electrospun cellulose acetate nanofibers as potential wound dressing materials. Polym. Adv. Technol. 2019, 30, 1135–1147. [Google Scholar] [CrossRef]
- Dong, W.H.; Liu, J.X.; Mou, X.J.; Liu, G.S.; Huang, X.W.; Yan, X.; Ning, X.; Russell, S.J.; Long, Y.Z. Performance of polyvinyl pyrrolidone-isatis root antibacterial wound dressings produced in situ by handheld electrospinner. Colloids Surfaces B Biointerfaces 2020, 188, 110766. [Google Scholar] [CrossRef]
- Yang, J.; Wang, K.; Yu, D.G.; Yang, Y.; Bligh, S.W.A.; Williams, G.R. Electrospun Janus nanofibers loaded with a drug and inorganic nanoparticles as an effective antibacterial wound dressing. Mater. Sci. Eng. C 2020, 111, 110805. [Google Scholar] [CrossRef]
- Thakur, R.A.; Florek, C.A.; Kohn, J.; Michniak, B.B. Electrospun nanofibrous polymeric scaffold with targeted drug release profiles for potential application as wound dressing. Int. J. Pharm. 2008, 364, 87–93. [Google Scholar] [CrossRef]
- Kim, K.; Luu, Y.K.; Chang, C.; Fang, D.; Hsiao, B.S.; Chu, B.; Hadjiargyrou, M. Incorporation and controlled release of a hydrophilic antibiotic using poly(lactide-co-glycolide)-based electrospun nanofibrous scaffolds. J. Control. Release 2004, 98, 47–56. [Google Scholar] [CrossRef]
- Amrutiya, N.; Bajaj, A.; Madan, M. Development of microsponges for topical delivery of mupirocin. AAPS PharmSciTech 2009, 10, 402–409. [Google Scholar] [CrossRef] [Green Version]
- Dürrigl, M.; Kwokal, A.; Hafner, A.; Šegvić Klarić, M.; Dumičić, A.; Cetina-Čižmek, B.; Filipović-Grčić, J. Spray dried microparticles for controlled delivery of mupirocin calcium: Process-tailored modulation of drug release. J. Microencapsul. 2011, 28, 108–121. [Google Scholar] [CrossRef]
- Elsner, J.J.; Berdicevsky, I.; Zilberman, M. In vitro microbial inhibition and cellular response to novel biodegradable composite wound dressings with controlled release of antibiotics. Acta Biomater. 2011, 7, 325–336. [Google Scholar] [CrossRef]
- Khaled, S.A.; Alexander, M.R.; Irvine, D.J.; Wildman, R.D.; Wallace, M.J.; Sharpe, S.; Yoo, J.; Roberts, C.J. Extrusion 3D Printing of Paracetamol Tablets from a Single Formulation with Tunable Release Profiles Through Control of Tablet Geometry. AAPS PharmSciTech 2018, 19, 3403–3413. [Google Scholar] [CrossRef] [Green Version]
- Real, J.P.; Camacho, N.; Barberis, E.; Palma, S.D. Modified-release 3D printed tablets: Challenges and opportunities based on geometry and materials. J. 3D Print. Med. 2018, 2, 93–95. [Google Scholar] [CrossRef]
- Xu, X.; Zhao, J.; Wang, M.; Wang, L.; Yang, J. 3D Printed Polyvinyl Alcohol Tablets with Multiple Release Profiles. Sci. Rep. 2019, 9, 12487. [Google Scholar] [CrossRef]
- Auvinen, V.V.; Virtanen, J.; Merivaara, A.; Virtanen, V.; Laurén, P.; Tuukkanen, S.; Laaksonen, T. Modulating sustained drug release from nanocellulose hydrogel by adjusting the inner geometry of implantable capsules. J. Drug Deliv. Sci. Technol. 2020, 57, 101625. [Google Scholar] [CrossRef]
- Pushparaj, M.; Ranganathan, R.; Ganesan, S. Design and development of drug delivery system for chronic wound using additive manufacturing. In 3D Printing and Additive Manufacturing Technologies; Springer: Singapore, 2018; pp. 119–126. ISBN 9789811303050. [Google Scholar]
- Long, J.; Etxeberria, A.E.; Nand, A.V.; Bunt, C.R.; Ray, S.; Seyfoddin, A. A 3D printed chitosan-pectin hydrogel wound dressing for lidocaine hydrochloride delivery. Mater. Sci. Eng. C 2019, 104, 109873. [Google Scholar] [CrossRef] [PubMed]
- Shi, G.; Wang, Y.; Derakhshanfar, S.; Xu, K.; Zhong, W.; Luo, G.; Liu, T.; Wang, Y.; Wu, J.; Xing, M. Biomimicry of oil infused layer on 3D printed poly(dimethylsiloxane): Non-fouling, antibacterial and promoting infected wound healing. Mater. Sci. Eng. C 2019, 100, 915–927. [Google Scholar] [CrossRef]
- Chinga-Carrasco, G.; Ehman, N.V.; Filgueira, D.; Johansson, J.; Vallejos, M.E.; Felissia, F.E.; Håkansson, J.; Area, M.C. Bagasse—A major agro-industrial residue as potential resource for nanocellulose inks for 3D printing of wound dressing devices. Addit. Manuf. 2019, 28, 267–274. [Google Scholar] [CrossRef]
- Maver, T.; Smrke, D.M.; Kurečič, M.; Gradišnik, L.; Maver, U.; Kleinschek, K.S. Combining 3D printing and electrospinning for preparation of pain-relieving wound-dressing materials. J. Sol-Gel Sci. Technol. 2018, 88, 33–48. [Google Scholar] [CrossRef]
- Meininger, S.; Vorndran, E.; Castilho, M.; Fernandes, P.R.; Gbureck, U. Low temperature 3D printing of drug loaded bioceramic scaffolds and implants. In Computational Methods in Applied Sciences; Springer: Cham, Switzerland, 2019; Volume 51, pp. 51–66. [Google Scholar]
- Bhattacharyya, S.S.; Paul, S.; De, A.; Das, D.; Samadder, A.; Boujedaini, N.; Khuda-Bukhsh, A.R. Poly (lactide-co-glycolide) acid nanoencapsulation of a synthetic coumarin: Cytotoxicity and bio-distribution in mice, in cancer cell line and interaction with calf thymus DNA as target. Toxicol. Appl. Pharmacol. 2011, 253, 270–281. [Google Scholar] [CrossRef] [PubMed]
- Stewart, S.A.; Dom, J.; Donnelly, R.F.; Larrañeta, E. Implantable polymeric drug delivery devices: Classification, manufacture, materials, and clinical applications. Polymers 2018, 10, 1379. [Google Scholar] [CrossRef] [PubMed] [Green Version]
- Hetem, D.J.; Bonten, M.J.M. Clinical relevance of mupirocin resistance in Staphylococcus aureus. J. Hosp. Infect. 2013, 85, 249–256. [Google Scholar] [CrossRef]
- Gisby, J.; Bryant, J. Efficacy of a new cream formulation of mupirocin: Comparison with oral and topical agents in experimental skin infections. Antimicrob. Agents Chemother. 2000, 44, 255–260. [Google Scholar] [CrossRef] [Green Version]
- Naseri, E.; Butler, H.; Macnevin, W.; Ahmed, M.; Ahmadi, A.; Naseri, E.; Butler, H.; Macnevin, W.; Ahmed, M.; Ahmadi, A.; et al. Low-temperature solvent-based 3D printing of PLGA: A parametric printability study printability study. Drug Dev. Ind. Pharm. 2020, 46, 173–178. [Google Scholar] [CrossRef]
- EUCAST 2020 Testing Breakpoint Tables for Interpretation of MICs and Zone Diameters. Available online: Https://Www.Eucast.Org/Ast_of_Bacteria/0–77 (accessed on 7 September 2020).
- CLSI. Performance Standards for Antimicrobial Susceptibility Testing, 30th ed.; CLSI Supplement M100; Clinical and Laboratory Standards Institute: Annapolis Junction, MD, USA, 2020. [Google Scholar]
- Available online: https://imagej.net/Fiji (accessed on 31 May 2019).
- Di, J.; Yao, S.; Ye, Y.; Cui, Z.; Yu, J.; Ghosh, T.K.; Zhu, Y.; Gu, Z. Stretch-Triggered Drug Delivery from Wearable Elastomer Films Containing Therapeutic Depots. ACS Nano 2015, 9, 9407–9415. [Google Scholar] [CrossRef]
- Weisman, J.A.; Ballard, D.H.; Jammalamadaka, U.; Tappa, K.; Sumerel, J.; D’Agostino, H.B.; Mills, D.K.; Woodard, P.K. 3D Printed Antibiotic and Chemotherapeutic Eluting Catheters for Potential Use in Interventional Radiology: In Vitro Proof of Concept Study. Acad. Radiol. 2018, 1–5. [Google Scholar] [CrossRef]
- Jain, R.A. The manufacturing techniques of various drug loaded biodegradable poly(lactide-co-glycolide) (PLGA) devices. Biomaterials 2000, 21, 2475–2490. [Google Scholar] [CrossRef]
- Chew, S.A.; Arriaga, M.A.; Hinojosa, V.A. Effects of surface area to volume ratio of PLGA scaffolds with different architectures on scaffold degradation characteristics and drug release kinetics. J. Biomed. Mater. Res. Part A 2016, 104, 1202–1211. [Google Scholar] [CrossRef]
- Skidmore, S.; Hadar, J.; Garner, J.; Park, H.; Park, K.; Wang, Y.; Jiang, X. (Jeff) Complex sameness: Separation of mixed poly(lactide-co-glycolide)s based on the lactide:Glycolide ratio. J. Control. Release 2019, 300, 174–184. [Google Scholar] [CrossRef] [PubMed]

| Biomaterial Ink | L:G | Molecular Weight (kDa) | Mupirocin in PLGA (% w/w) |
|---|---|---|---|
| LG5050-20 | 50:50 | 85–100 | 20 |
| LG6040-20 | 60:40 | 100–200 | 20 |
| LG8515-20 | 85:15 | 100–200 | 20 |
| LG8515-30 | 85:15 | 100–200 | 30 |
| LG8515-40 | 85:15 | 100–200 | 40 |
© 2020 by the authors. Licensee MDPI, Basel, Switzerland. This article is an open access article distributed under the terms and conditions of the Creative Commons Attribution (CC BY) license (http://creativecommons.org/licenses/by/4.0/).
Share and Cite
Naseri, E.; Cartmell, C.; Saab, M.; Kerr, R.G.; Ahmadi, A. Development of 3D Printed Drug-Eluting Scaffolds for Preventing Piercing Infection. Pharmaceutics 2020, 12, 901. https://doi.org/10.3390/pharmaceutics12090901
Naseri E, Cartmell C, Saab M, Kerr RG, Ahmadi A. Development of 3D Printed Drug-Eluting Scaffolds for Preventing Piercing Infection. Pharmaceutics. 2020; 12(9):901. https://doi.org/10.3390/pharmaceutics12090901
Chicago/Turabian StyleNaseri, Emad, Christopher Cartmell, Matthew Saab, Russell G. Kerr, and Ali Ahmadi. 2020. "Development of 3D Printed Drug-Eluting Scaffolds for Preventing Piercing Infection" Pharmaceutics 12, no. 9: 901. https://doi.org/10.3390/pharmaceutics12090901
APA StyleNaseri, E., Cartmell, C., Saab, M., Kerr, R. G., & Ahmadi, A. (2020). Development of 3D Printed Drug-Eluting Scaffolds for Preventing Piercing Infection. Pharmaceutics, 12(9), 901. https://doi.org/10.3390/pharmaceutics12090901







